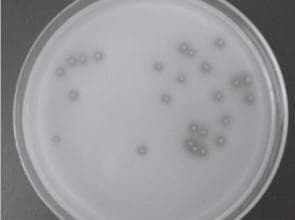

Lo existente sobre la tierra, pudiéramos observarlo solo de mirar a nuestro alrededor, así vemos panoramas de todo tipo, que van desde los que incluyen a la flora y la fauna, hasta las construcciones hechas por el hombre para la subsistencia sobre él. Sin embargo, lo que está bajo el suelo, no puede observarse con igual facilidad, a pesar que constituye la base fundamental del ecosistema.
En el medio edáfico, ocurren una serie de relaciones de alimentación, muerte, degradación y convivencia a través de la interacción de sus componentes (partículas minerales, materia orgánica, organismos vivos, gases y agua. Los organismos vivos, fundamentalmente los microorganismos, juegan un papel primordial en la dinámica de las transformaciones que allí ocurren. Se ha demostrado, que la distribución de las bacterias está altamente organizada, y que esta estructuración es importante para la funcionalidad del suelo; la presencia de raíces, pequeños agregados, nutrientes, poros, entre otros, son factores que parecen gobernar la distribución de las bacterias en los micro hábitat.
En los últimos años, la sostenibilidad agrícola ha cobrado especial interés al conocer de su incidencia directa en los beneficios para el hombre y para el balance ecológico y agroecológico. Para fortalecer los sistemas agrícolas sostenibles, es necesario conocer los componentes que lo integran y que puedan determinar la funcionalidad de los mismos. De ahí la importancia de reconocer que la productividad de los cultivos viene dada por la fertilidad del suelo, que puede ser evaluada por sus características físicas, químicas y biológicas.
Cuando en el sistema se introducen las plantas, la situación de los microorganismos cambia drásticamente, por el aporte de sustratos energéticos. En 1904 Lorenz Hiltner, introdujo el término rizosfera para designar la porción de tierra que rodea a las raíces y que resulta afectada por el desarrollo de éstas. Es la región que se extiende hasta unos pocos milímetros de la superficie de la raíz y dónde se producen interacciones entre la planta y los microorganismos.
Las poblaciones de microorganismos alrededor de las raíces alcanzan cifras de cientos de millones de células por cm3, densidad que resulta unas 10 a 1000 veces mayor que la parte no rizosférica. Se calcula que el suministro de compuestos orgánicos a la zona de las raíces es de entre 50 y 100 mg de materia orgánica por gramo de raíz.
En contrapartida, los microorganismos desarrollan en la rizosfera actividades metabólicas de las que se benefician las plantas: transformaciones de la materia orgánica, movilización de nutrientes inorgánicos, producción de sustancias promotoras del crecimiento vegetal, antagonismos frente a patógenos, entre otros.
Las condiciones bióticas y abióticas del ecosistema favorecen el desarrollo de determinados grupos microbianos que participan directamente en los diferentes procesos biológicos y bioquímicos y pueden éstos, favorecer o no el desarrollo de fenómenos beneficiosos o perjudiciales al propio suelo y a las plantas. En este trabajo nos referiremos a aquellos microorganismos que con un buen uso y manejo de los mismos, pueden aportar beneficios ecológicos al sistema y que han nombrado exitosamente, los estudiosos del tema, las PGPR.
¿Qué son las PGPR?
Kloepper definió en 1978, a las bacterias de vida libre, encontradas en la rizosfera de las plantas como Rizobacteria Promotora del Crecimiento Vegetal (PGPR, por sus siglas en inglés, que viene de la denominación Plant Growth Promoting Rhizobacteria) éstas demostraron ser organismos altamente eficientes para aumentar el crecimiento de las plantas e incrementar sus defensas frente a otros microorganismos causantes de enfermedades.
Dado al gran desarrollo que en las últimas décadas han tenido los estudios relacionados con este tipo de bacterias y su uso en la agricultura, se ha propuesto la separación en dos grupos, uno que enmarca solamente a las bacterias que inciden en el crecimiento vegetal y que se han dado a llamar Bacterias Promotoras del Crecimiento (PGPB, por sus siglas en inglés, que viene de la denominación Plant Growth Promoting Bacteria) y otro que incluye aquellas bacterias que controlan fitopatógenos, ya sea produciendo sustancias inhibitorias o incrementando la resistencia natural de la planta y a las que se les denominan Biocontrol-PGPB. Esta forma de clasificación permite la inclusión en el primer grupo a aquellas bacterias asociativas, fijadoras de nitrógeno. La polémica en cuanto a los términos continúa y por el momento, se sigue reconociendo, de forma general, a este tipo de bacterias beneficiosas como PGPR.
Uno de los requerimientos más importantes para que una bacteria sea considerada como PGPR es el tiempo de permanencia en la rizosfera después de la inoculación. Una población introducida que declina rápidamente en el tiempo, tendrá una baja habilidad de competencia con la flora nativa. Otra característica, no menos importante, es la posibilidad de colonizar la superficie de las raíces para ejercer un efecto fisiológico directo sobre el crecimiento de las plantas. Por último, que esas PGPR utilizadas no provoquen daño ni al suelo, ni a las plantas, ni a los animales y al hombre.
Desde hace varias décadas, se vienen desarrollando estudios sobre cómo y porqué estas PGPR son beneficiosas a las plantas. Se conoce que la estimulación se desarrolla a través de dos mecanismos fundamentales, uno directo y otro indirecto.
Estimulación directa: El metabolito producido por la bacteria es capaz de estimular el crecimiento del vegetal. A través de este mecanismo se desarrollan procesos tales como:
- Fijación de nitrógeno. Las leguminosas tienen la capacidad de establecer una asociación simbiótica con las bacterias de la familia Rhizobiaceae comúnmente conocidas como Rhizobius. Estas bacterias inducen en la planta la formación de estructuras especializadas, denominadas nódulos, en donde se alojan como simbiontes intracelulares y fijan nitrógeno atmosférico que es utilizado por la planta. Por medio del manejo de los sistemas simbióticos fijadores de nitrógeno (Rhizobium-leguminosa, Frankia-casuarina, Anabaena-Azolla) es posible contribuir al enriquecimiento de la fertilidad del suelo. Existen otras PGPR de vida libre capaces de reducir el nitrógeno atmosférico. Tal es el caso de Azospirillum, Azotobacter, Gluconacetobacter, Beijerinkia, entre otras. Todas ellas además, poseen otros mecanismos tan o mas importantes con los cuales aumentan la productividad de los cultivos
- Producción de sustancias reguladoras del crecimiento. El desarrollo vegetal se encuentra regulado por la acción de sustancias químicas que activan o inhiben determinados procesos fisiológicos. Estas sustancias se denominan fitohormonas, que se definen como reguladores producidos por las plantas y que a bajas concentraciones regulan los procesos fisiológicos de éstas. Dentro de las fitohormonas que estimulan el crecimiento de las plantas se destacan las auxinas, las giberelinas y las citoquininas. La respuesta a cada una de ellas esta condicionada por factores externos e internos como la edad de la planta, el estadio fisiológico y las condiciones ambientales, entre otras. Los mecanismos aún no están muy definidos ya que no hay un modo único de acción para cada sustancia.
Estimulación indirecta: La estimulación es indirecta cuando la bacteria es capaz de liberar una o varias sustancias o metabolitos que intervienen en procesos que mejoran el crecimiento vegetal. Los mecanismos fundamentales de estimulación indirecta se pueden resumir en los siguientes:
- Producción de sustancias que movilizan nutrientes (ácidos orgánicos, enzimas, aminoácidos, entre otras). Estas sustancias son liberadas al medio y son capaces de movilizar elementos nutricionales como el hierro, el fósforo y el aluminio. Ejemplo de ello, lo constituyen las bacterias solubilizadoras de fósforo, las cuales a través de la secreción de ácidos orgánicos, solubilizan el fósforo mineral y mediante la acción hidrolítica de las enzimas fosfatasas, mineralizan el fósforo orgánico.
- Producción de antibióticos. La capacidad de las PGPR de generar sustancias antibióticas pueden producir dos efectos antagónicos entre si: Los procesos inhibitorios que retardan el desarrollo y elongación de las raíces y los que aumentan el crecimiento por inhibición de patógenos.
- Producción de sideróforos. Los sideróforos son sustancias de bajo peso molecular que tienen alta afinidad por el hierro. En condiciones de escasez de hierro, las bacterias productoras de estas sustancias, secuestran al elemento, convirtiéndolo en factor limitante para grupos de microorganismos patógenos hierro-dependientes.
- Producción de sustancias que inducen la resistencia sistémica en algunas plantas. Las bacterias PGPR amplifican el mecanismo de la planta para la defensa frente a diferentes enfermedades, fundamentalmente en aquellas que la tienen latente o de expresión lenta.
- Síntesis de sustancias con actividad para el control de patógenos. Síntesis de enzimas que hidrolizan la pared de algunos hongos que son patógenos y otras sustancias que controlan el desarrollo de plagas.
Utilización de las PGPR en la agricultura
La inoculación con bacterias beneficiosas proviene de finales del siglo XIX, donde la práctica de mezclar suelo inoculado de forma natural con semillas, se convirtió en un método recomendado para la inoculación de leguminosas en los Estados Unidos. Mas tarde, se registró la primera patente (NITRAGIN) para inoculación de leguminosas con Rhizobium sp.. y se desarrollaron productos con cepas de Bacillus megaterium y Azotobacter sp. En los años 70 ocurren los dos mayores descubrimientos relacionados con la tecnología de inoculación: Redescubrimiento del Azospirillum y la acción de los grupos de Pseudomonas fluorescens y Pseudomona putida, como agentes de control biológico. En los últimos años se evaluaron otros géneros de bacterias por su efectividad, como son Bacillus, Flavobacterium, Gluconacetobacter, entre otros.
En la actualidad, en el mercado de los inoculantes se imponen los productos elaborados a base de Rhizobium sp. y Bradyrhizobium sp. y se desarrollan estudios con el objetivo de evaluar el efecto de otras bacterias sobre el crecimiento de las plantas y el rendimiento de los cultivos, a fin de disminuir el uso de los fertilizantes minerales y otros agroquímicos. Aun cuando el uso comercial de las PGPR se puede decir que es incipiente, existen compañías que hace algunos años han lanzado al mercado productos elaborados con este tipo de bacterias.
Existen dos clases de inoculantes: los que se utilizan para el control de enfermedades y los que tienen como objetivo fundamental la estimulación del crecimiento de las plantas. Con respecto a los primeros, hay productos a base de bacterias y hongos que controlan enfermedades Estos agentes de control biológico permiten reducir o eliminar las aplicaciones de funguicidas. En cuanto a los inoculantes que estimulan el crecimiento, se han creado diversos productos, tales como aquellos a base de bacterias y hongos, que favorecen la asimilación del fósforo por parte de las plantas, de bacterias que hacen asimilable el nitrógeno atmosférico y las que incrementan la captación de nitrógeno por parte de las raíces.
Planta de fermentación
La mayoría de los inoculantes a base de bacterias promotoras del crecimiento, se elaboran mediante técnicas de la biotecnología convencional, donde los procesos de fermentación son la herramienta fundamental. La selección y estudio de las bacterias PGPR, de forma general se han realizado en los centros de investigación y en universidades y posteriormente se han autorizado a empresas para su comercialización. Una vez seleccionada la cepa a utilizar, y las materias primas para el enriquecimiento de los medios de cultivos que garanticen el desarrollo de la misma, pasan por un proceso de crecimiento microbiano que genera la liberación de metabolitos, que posteriormente, juegan un papel importante en la estimulación del desarrollo de los cultivos. El proceso no culmina, hasta que los caldos de cultivos son formulados adecuadamente para garantizar, no solo la estabilidad del producto en el tiempo, si no que se mantenga la viabilidad y la actividad metabólica de las bacterias que lo contienen. La comercialización de productos líquidos aún se mantiene en aquellos países donde las técnicas culturales lo exigen. Sin embargo, los microorganismos soportados en lechos sólidos como es la turba, han demostrado mayor estabilidad en el tiempo que los líquidos. En la actualidad se estudian otros soportes para los PGPR. Por ejemplo, el grupo de investigadores liderado por el Dr Bashan en México tiene progresos muy promisorios con la utilización de bacterias encapsuladas en matriz de alginato, lo que significaría un avance científico técnico importante en el campo de la biotecnología agrícola.
Cuba, ha logrado importantes avances en este campo. Los institutos de investigación relacionados con la rama agrícola, desde hace varias décadas comenzaron a desarrollar inoculantes para la agricultura, basados en las potencialidades de las PGPR con énfasis en el manejo responsable del suelo y en la sostenibilidad medioambiental.
Actualmente, existe una variedad de inoculantes de uso agrícola que están disponibles en el país, entre los que se encuentran: DIMARGON (Azotobacter sp.); BIOFERT (Rhizobium phaseoli); AZOSPIRILLUM (Azospirillum brasilense) AZOFER (Bradyrizobium sp.), AZOFER (Rhizobium sp.) y AZOFER (Azospirillum sp.); FOSFORINA (Pseudomonas sp.).
Muchos de estos productos se comercializan en el exterior y aunque los resultados aun son discretos, han demostrado su efectividad en otras regiones y condiciones edafoclimáticas.
Este biofertilizante constituye, en la actualidad, uno de los productos que marca el liderazgo en la competencia que existe entre las empresas que comercializan productos a base de microorganismos PGPR en Argentina y gran parte del América del Sur.
Consideraciones finales
La adopción y uso eficaz de biofertilizantes en la agricultura está llamada a ser una de las tecnologías clave para asegurar la sustentabilidad y productividad de este sector tan importante para la economía y la sociedad. La posibilidad de obtener elevados rendimientos agrícolas y al mismo tiempo preservar el medio ambiente está irremediablemente ligada al uso generalizado de estos productos, como alternativa al uso masivo de plaguicidas y fertilizantes de origen químico, que son costosos y tienen un impacto muy negativo sobre la salud y el medio ambiente.
Para el logro exitoso del incremento del uso de estas técnicas, la comunidad científica expresa su sentir y preocupaciones, en diferentes redes regionales creadas para ello. Unificar criterios de selección de cepas beneficiosas, calidad de los productos que se comercializan y mejorar los soportes para garantizar mayor efecto de los mismos, son algunos de los criterios que defienden para de forma oficial y con carácter regulatorio lograr una inserción irreversible de las PGPR, que sin dudas, será un aporte importante en el desarrollo de la agricultura del siglo XXI.
Bibliografía
1. Bach, T., Díaz, M., Ferreira, A., Laurent, A. (2007). Estudio de las características de promoción del desarrollo vegetal de Pseudomonas fluorescens utilizada en el biofertilizante Rizofos. VI Reunión Nacional Cientifico Técnica de Biología de Suelo. VI Encuentro sobre Fijación Biologíca de Nitrógeno, ISBN 978-950-665437-5. Río Cuarto, Córdoba, Argentina.
2. Bashan, Y., y Holguin, G. (1998). Proposal for the division of Plant Growth-Promoting Rhizobacteria into two classifications: biocontrol-PGPB (Plant Growth-Promoting Bacteria) and PGPB. Soil Biology and Biochemistry 30: 1225-1228.
3. O’Brien, J. B., y Kenney, D. S. (2000). International considerations for the development of PGPR products. Fifth international PGPR workshop (Plant Growth-Promoting Rhizobacteria). Villa Carlos Paz, Córdoba, Argentina.